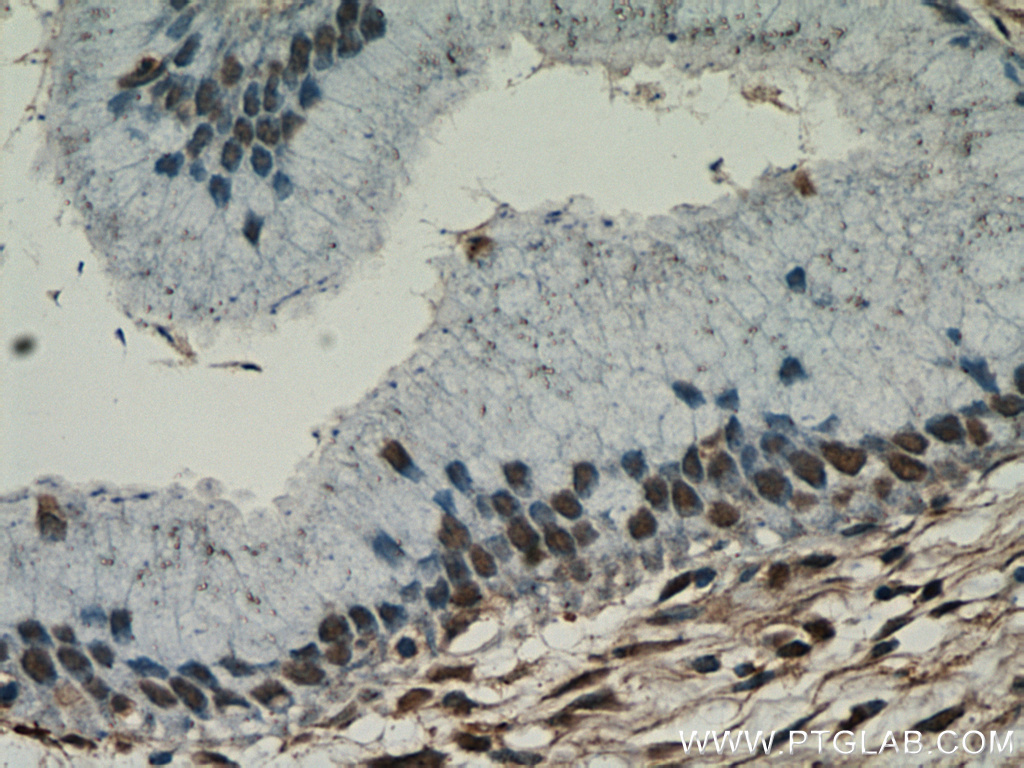

验证数据展示
经过测试的应用
| Positive WB detected in | mouse spleen tissue |
| Positive IHC detected in | human prostate cancer tissue, human cervix tissue Note: suggested antigen retrieval with TE buffer pH 9.0; (*) Alternatively, antigen retrieval may be performed with citrate buffer pH 6.0 |
| Positive IF/ICC detected in | HeLa cells |
推荐稀释比
| 应用 | 推荐稀释比 |
|---|---|
| Western Blot (WB) | WB : 1:500-1:1000 |
| Immunohistochemistry (IHC) | IHC : 1:50-1:500 |
| Immunofluorescence (IF)/ICC | IF/ICC : 1:200-1:800 |
| It is recommended that this reagent should be titrated in each testing system to obtain optimal results. | |
| Sample-dependent, Check data in validation data gallery. | |
产品信息
55471-1-AP targets ESR2 Beta 6 in WB, IHC, IF/ICC, ELISA applications and shows reactivity with human, mouse samples.
| 经测试应用 | WB, IHC, IF/ICC, ELISA Application Description |
| 文献引用应用 | WB, IF, IHC |
| 经测试反应性 | human, mouse |
| 文献引用反应性 | human, mouse |
| 免疫原 |
Peptide 种属同源性预测 |
| 宿主/亚型 | Rabbit / IgG |
| 抗体类别 | Polyclonal |
| 产品类型 | Antibody |
| 全称 | estrogen receptor 2 (ER beta) |
| 别名 | ER BETA, Erb, ESR BETA, ESR2, ESR2 Beta 6, ESRB, ESTRB, estrogen receptor 2 (ER beta), Estrogen receptor beta, NR3A2 |
| 计算分子量 | 42 kDa |
| 观测分子量 | 42 kDa |
| GenBank蛋白编号 | NM_001437 |
| 基因名称 | ESR2 |
| Gene ID (NCBI) | 2100 |
| RRID | AB_2881344 |
| 偶联类型 | Unconjugated |
| 形式 | Liquid |
| 纯化方式 | Antigen affinity purification |
| UNIPROT ID | Q92731 |
| 储存缓冲液 | PBS with 0.02% sodium azide and 50% glycerol, pH 7.3. |
| 储存条件 | Store at -20°C. Aliquoting is unnecessary for -20oC storage. |
背景介绍
Estrogen receptor-beta (ESR2) is a member of the superfamily of nuclear receptors, which can transduce extracellular signals into transcriptional responses. It binds estrogens with an affinity similar to that of ESR1, and activates expression of reporter genes containing estrogen response elements (ERE) in an estrogen-dependent manner. DNA-binding by ESR1 and ESR2 is rapidly lost at 37 degrees Celsius in the absence of ligand while in the presence of 17 beta-estradiol and 4-hydroxy-tamoxifen loss in DNA-binding at elevated temperature is more gradual
实验方案
| Product Specific Protocols | |
|---|---|
| IF protocol for ESR2 Beta 6 antibody 55471-1-AP | Download protocol |
| IHC protocol for ESR2 Beta 6 antibody 55471-1-AP | Download protocol |
| WB protocol for ESR2 Beta 6 antibody 55471-1-AP | Download protocol |
| Standard Protocols | |
|---|---|
| Click here to view our Standard Protocols |